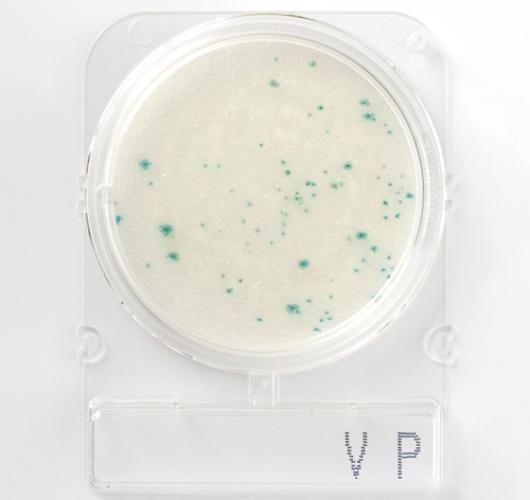
Подложки парагемолитический вибрион - Compact Dry VP

Подложки парагемолитический вибрион - Compact Dry VP
Подложки парагемолитический вибрион - Compact Dry VP
Парагемолитический Вибрион (Vibrio parahaemolyticus) — это патоген, который может развиваться в соленой воде и заражать все морепродукты и моллюсков. Употребление зараженных сырых или недоваренных морепродуктов может вызвать инфекцию.
Таким образом, в рамках безопасности пищевых продуктов контроль Парагемолитический Вибрион должен осуществляться на каждом этапе производства пищевых продуктов. Он считается параметром анализа морепродуктов, моллюсков и всех продуктов на основе морепродуктов.
Виды вибрионов образуют на среде белые колонии. Парагемолитический Вибрион можно легко отличить от других видов вибрионов по образованию сине-зеленых или синих колоний на среде.
Цвет колоний: синий / зеленый.
Температура и время инкубации: 35–37°C / 24 часа.
Срок годности: 12–18 месяцев / 5–30°C.